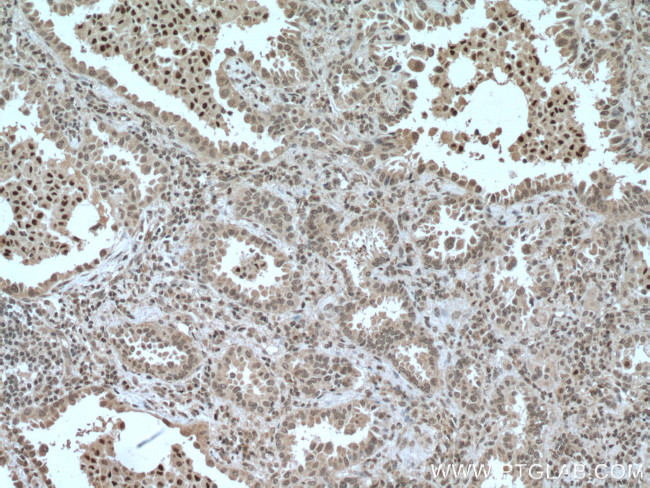
CEBPB Antibody in Immunohistochemistry (Paraffin) (IHC (P))

Search
Proteintech
CEBPB Monoclonal Antibody (2B6E10)
{{$productOrderCtrl.translations['antibody.pdp.commerceCard.promotion.promotions']}}
{{$productOrderCtrl.translations['antibody.pdp.commerceCard.promotion.viewpromo']}}
{{$productOrderCtrl.translations['antibody.pdp.commerceCard.promotion.promocode']}}: {{promo.promoCode}} {{promo.promoTitle}} {{promo.promoDescription}}. {{$productOrderCtrl.translations['antibody.pdp.commerceCard.promotion.learnmore']}}
产品信息
66649-1-IG
种属反应
宿主/亚型
分类
类型
克隆号
抗原
偶联物
形式
浓度
规格
纯化类型
保存液
内含物
保存条件
运输条件
产品详细信息
Immunogen sequence: MQRLVAWDP ACLPLPPPPP AFKSMEVANF YYEADCLAAA YGGKAAPAAP PAARPGPRPP AGELGSIGDH ERAIDFSPYL EPLGAPQAPA PATATDTFEA APPAPAPAPA SSGQHHDFLS DLFSDDYGGK NCKKPAEYGY VSLGRLGAAK GALHPGCFAP LHPPPPPPPP PAELKAEPGF EPADCKRKEE AGAPGGGAGM AAGFPYALRA YLGYQAVPSG SSGSLSTSSS SSPPGTPSPA DAKAPPTACY AGAAPAPSQV KSKAKKT (1-266 aa encoded by BC007538)
靶标信息
This gene belongs to the forkhead family of transcription factors which is characterized by a distinct DNA-binding forkhead domain. The specific function of this gene has not yet been determined; however, it may play a role in the development of mesenchymal tissues.
仅用于科研。不用于诊断过程。未经明确授权不得转售。
生物信息学
蛋白别名: AGP/EBP; C EBP; C/EBP BETA; C/EBP-related protein 2; CCAAT/enhancer binding protein (C/EBP), beta; CCAAT/enhancer-binding protein beta; IL-6DBP; interleukin 6-dependent DNA-binding protein; Interleukin-6-dependent-binding protein; LAP; LIP; Liver activator protein; Liver-enriched inhibitory protein; Liver-enriched transcriptional activator; Nuclear factor NF-IL6; nuclear factor of interleukin 6; nuclear factor-IL6; nuclear protein Il6; OTTMUSP00000017503; SF-B; Silencer factor B; TCF-5; Transcription factor 5; transcription factor C/EBP beta; unnamed protein product
基因别名: C/EBP-beta; C/EBPbeta; CEBPB; CRP2; IL-6DBP; IL6DBP; LAP; LIP; NF-IL6; NF-M; Nfil6; PP9092; Sfb; TCF5
UniProt ID: (Human) P17676, (Mouse) P28033, (Rat) P21272
Entrez Gene ID: (Human) 1051, (Mouse) 12608, (Rat) 24253